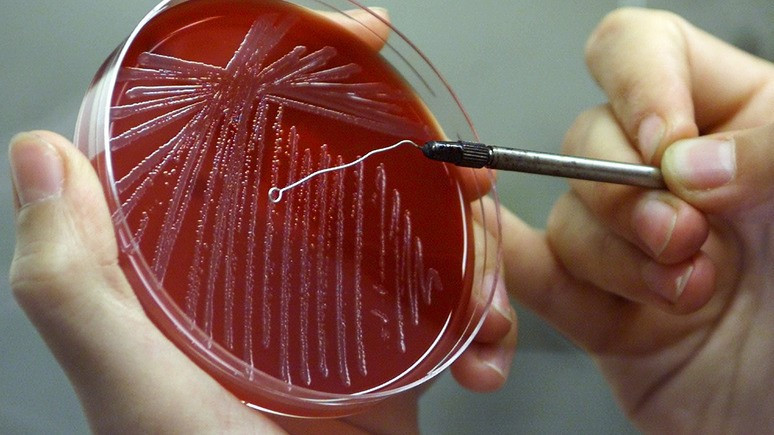
Вести: в украинском Тернополе обнаружили сибирскую язву

Вести: австрийский фермер запер 15 украинских рабочих на карантин

Австрийский фермер закрыл сезонных рабочих с Украины в их местах проживания, опасаясь, что они заражены коронавирусом. Как пишут «Вести», соответствующую информацию подтвердила консул посольства Украины в Австрии Мирослава Зинкевич.
«Сами украинцы за помощью в украинское посольство не обращались», — отметила консул.
Инцидент произошёл на предприятии по переработке овощей в округе Линц-Ланд. Владелец фермы решил временно закрыть в помещениях сезонных рабочих с Украины, которые, по его мнению, были инфицированы коронавирусом и могли заразить других сотрудников.
Двенадцать человек согласились, однако трое были против подобного ограничения свободы передвижения и написали жалобу на фермера в земельную службу по защите прав рабочих.
Открыто уголовное дело по подозрению в незаконном лишении свободы. Расследование ведёт прокуратура округа.
Обсудим?
Смотрите также: